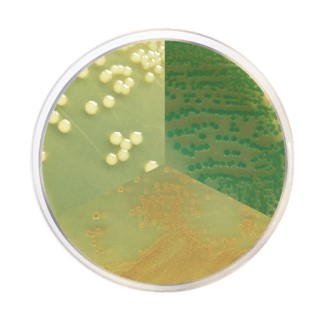
Climate Crisis vs Food Safety: Detection of Vibrio spp

Climate Crisis vs Food Safety: Detection of Vibrio spp
Although it may be difficult to comprehend, the climate crisis significantly raises the risk to food safety since some germs may flourish in these new environments.
For instance, vibriosis was an endemic illness in certain areas a few decades ago. It has, however, migrated to other nations due to climate change, leading to fresh outbreaks. The cause of this is an increase in ocean temperature, which makes it easier for organisms of the genus Vibrio spp. to reproduce.
Vibrio spp. and shellfish
Vibrio spp., which often exists in fresh and saltwater environments and favours mildly salty and warm temperatures, has the most impact on the fishing business.

Since they concentrate and grow in the guts of molluscs like oysters, clams, and mussels, these pathogens are typically detected in shellfish. However, exposure to polluted waterways also increases the risk of illness, making this issue important from both an environmental and a clinical standpoint.
V. cholerae, V. parahaemolyticus, V. alginolyticus, and V. vulnificus are the most common pathogenic species of Vibrio spp. Related to food safety. Cholerae and non-cholerae are two categories for bacterial classification. This distinction is crucial since it identifies the infection's origin, which is often different.
Gastroenteritis and, to a lesser extent, sepsis are frequently included in the clinical manifestations of infections brought on by Vibrio spp. Other symptoms, however, could appear depending on the species that causes the infection. According to the CDC, these Gram-negative bacteria infect 80,000 individuals yearly, and foodborne illnesses account for over 70% of these infections.
How is Vibrio detected?
The accepted procedure for finding Vibrio spp., including the pathogen V. vulnificus, has recently been updated. This technique uses a high-pH medium that takes advantage of the microorganism's ability to expand quickly in these circumstances:

As is customary for ISO procedures, isolation of calls for use in a second selective media is required. To acquire a preliminary result and facilitate the identification of the many species that would develop in different colours, we propose the CondaChrome® Vibrio
|
|
|
If you need more information about Vibrio spp. and food safety, contact our Sales team today.
|
To find out more: |